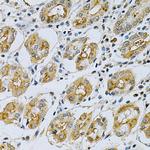
Maspin Antibody in Immunohistochemistry (Paraffin) (IHC (P))

Search
Invitrogen
Maspin Polyclonal Antibody
{{$productOrderCtrl.translations['antibody.pdp.commerceCard.promotion.promotions']}}
{{$productOrderCtrl.translations['antibody.pdp.commerceCard.promotion.viewpromo']}}
{{$productOrderCtrl.translations['antibody.pdp.commerceCard.promotion.promocode']}}: {{promo.promoCode}} {{promo.promoTitle}} {{promo.promoDescription}}. {{$productOrderCtrl.translations['antibody.pdp.commerceCard.promotion.learnmore']}}
图: 1 / 3
Maspin Antibody (PA5-89591) in IHC (P)

Please note: We are reviewing Western blot images included in the antibody testing data in our catalog, including those provided by third parties. Unless expressly labeled or annotated as “raw-unedited”, Western blot images included in the antibody testing data in our catalog may have been edited, optimized or otherwise adjusted for presentation.
产品信息
PA5-89591
宿主/亚型
分类
类型
抗原
偶联物
形式
浓度
规格
保存条件
运输条件
RRID
产品详细信息
Immunogen sequence: EKEPLGNVLF SPICLSTSLS LAQVGAKGDT ANEIGQVLHF ENVKDVPFGF QTVTSDVNKL SSFYSLKLIK RLYVDKSLNL STEFISSTKR PYAKELETVD FKDKLEETKG QINNSIKDLT DGHFENILAD NSVNDQTKIL VVNAAYFVGK WMKKFSESET KECPFRVNK; Positive Samples: HT-29, NIH/3T3; Cellular Location: extracellular space
靶标信息
SERPINB5 is a tumor suppressor. It blocks the growth, invasion, and metastatic properties of mammary tumors. As it does not undergo the S (stressed) to R (relaxed) conformational transition characteristic of active serpins, it exhibits no serine protease inhibitory activity.
仅用于科研。不用于诊断过程。未经明确授权不得转售。




